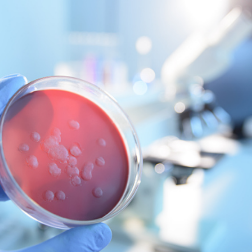
生物实验室何以遍布全球？美国，请回答！

连日来,围绕美国在乌克兰的生物实验室,疑云重重。
3月7日,俄罗斯国防部公布了在乌克兰缴获的文件:美国在乌境内控制了30多个生物实验室。2月24日起,这些实验室接到全面销毁生物试剂的命令。
美方指责俄罗斯散布“虚假信息”。白宫新闻秘书普萨基称,美国没有在任何地方开发或拥有生化武器。然而,美国副国务卿纽兰在听证会上承认,乌克兰有“生物研究设施”,美方正同乌方合作,防止那些“研究材料”落入俄罗斯军队手中。
美国白宫新闻发言人和副国务卿,是谁在说谎?
人们还在为美国自相矛盾的发言困惑之时,俄罗斯再次披露劲爆消息。10日,俄罗斯国防部发言人科纳申科夫在记者会上表示,美国在乌克兰的实验室中开展蝙蝠冠状病毒样本实验,目的是建立一个秘密传播致命病原体的机制。
对此,美国仍然遮遮掩掩,顾左右而言他。然而谎言掩盖不了事实。根据美国2021年底向《禁止生物武器公约》缔约国大会提交的文件,美方在乌克兰有26处实验室等合作设施,投入超过2亿美元。公开披露的消息表明,这些实验室按照美国国防部命令运行。美国国防部代表有权参与乌方设施活动,乌方须将境内所有危险病原体保存在美乌合作的实验室,须上交美国国防部索要的危险病原体,未经美方许可不得公开美方认定的“敏感信息”等关键内容。
实际上,美国在乌克兰的生物实验室只是冰山一角。美国国防部以“合作减少生物安全风险”“加强全球公共卫生”等名义,在全球30个国家控制了336个生物实验室,遍布非洲、欧洲、亚洲等地。这些实验室安全事故频发,给事发国带来深重灾难。
韩国媒体曾报道说,驻韩美军的生化武器实验室设在首尔龙山、釜山、群山和平泽四个美军基地。2009年至2014年,这些实验室共进行了至少15次危险的炭疽杆菌试验。2021年,韩国大韩消防安全教育文化协会对美军德特里克堡生物实验室提起诉讼。相关报道提及,美军自2013年6月起在韩秘密开展生化器研究,即“朱庇特”计划。“朱庇特”计划曝光后,美军不仅没有公开真实情况,而且无视韩国法律,逐年增运生化武器样品到韩国,危害民众生命健康安全。
2015年,美国一家生化中心在向驻韩美军基地寄出炭疽杆菌样本时还向韩国输送进了鼠疫杆菌,并且发生了配送事故。2018年,位于格鲁吉亚的卢格实验室也发生事故,在那里工作的两名菲律宾人死于“毒气中毒”。美国驻乌克兰大使馆官网文件表明,美国资助的一个实验室位于乌克兰第二大城市哈尔科夫。2016年1月,至少20名乌克兰士兵在那里死于类似感冒的病毒,还有200名士兵入院治疗。
美国遍布全球的生物实验真正的意图是什么?国际社会一直存在疑虑。这些实验室与一些危险疾病蔓延始发地分布情况高度吻合,对此,美国始终没有作出任何严肃回应。一向自诩信息透明的美国,为什么不愿开放海外生物实验室和德特里克堡实验室给国际专家独立调查,以回应国际社会关切?对于俄罗斯披露的消息大声喊冤的美国,为什么不公布乌克兰生物实验室的详细材料以证清白?美国驻乌克兰大使馆甚至一度删除乌克兰实验室相关材料,究竟想隐瞒什么?
生物武器是利用毒素、病原体从人体内部发动攻击的武器,其使用极其不人道。二战时期,日本731部队在中国发动惨无人道的细菌战,就是臭名昭著的例子。1975年,《禁止生物武器公约》签署,禁止发展、生产、取得或存储任何生物武器。然而美国是20年来独家反对建立《禁止生物武器公约》多边核查机制的国家。迄今,美国是唯一一个仍然拥有化学武器的国家。国际社会一再要求美国尽快完成库存化学武器的销毁工作,但美国的该项工作已经两次逾期。
荒谬的是,2003年,美国拿着一小袋洗衣粉,以“制造生化武器”为由入侵伊拉克,杀害大量平民,结果连一克证据都没找到。
如今,美国遍布全球的生物实验室在干什么?全世界都想知道答案。
来源:人民网
编辑:阮梓峰
本文链接:https://news.rednet.cn/content/2022/03/19/11026474.html